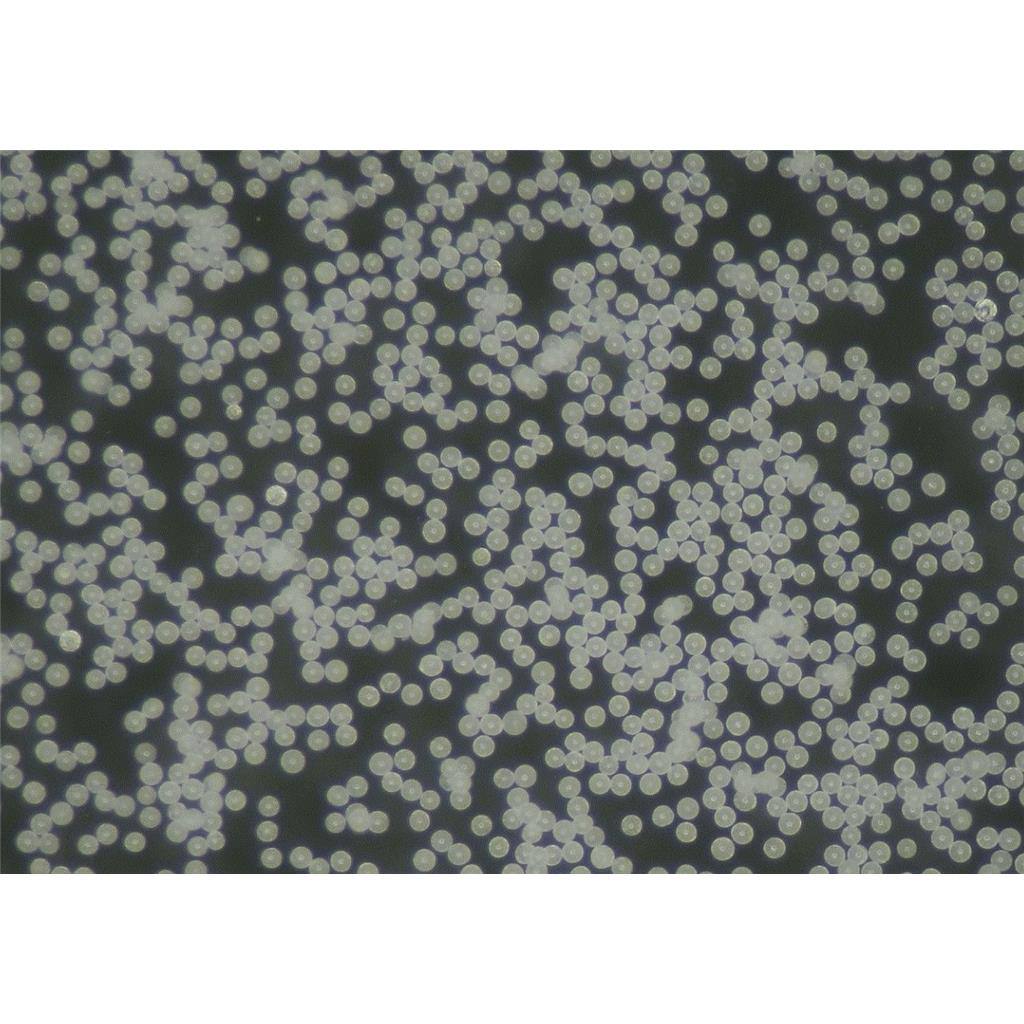
聚己内酯微球PCL微球30-50微米

聚己内酯微球PCL微球30-50微米
Polycaprolactone
¥400
1g
起订
浙江 更新日期:2026-04-03
产品详情:
- 中文名称:
- 聚己内酯
- 英文名称:
- Polycaprolactone
- CAS号:
- 24980-41-4
- 品牌:
- 品卓生物
- 产地:
- 浙江
- 纯度规格:
- 99%
- 别名:
- PCL微球
- 分子式:
- (C6H10O2)n
公司简介
主营:聚乳酸PLA、 聚左旋乳酸PLLA、聚消旋乳酸PDLLA、聚己内酯PCL、聚乙丙交酯PLGA等微球及多孔材料微球。
| 成立日期 | (5年) |
| 注册资本 | 陆佰万元整 |
| 员工人数 | 10-50人 |
| 年营业额 | ¥ 100万-300万 |
| 经营模式 | 工厂 |
| 主营行业 | 聚合物材料 |
聚己内酯相关厂家报价 更多
-

- 聚己内酯产品是由ε-己内酯开环聚合而得到的高分子量脂肪族聚酯
- 岳阳市巴陵佳云石化有限公司
- 2026-04-05
- 询价
-

- 聚己内酯
- 河南沃咖斯生物科技有限公司 VIP
- 2026-04-05
- 询价
-

- 聚己内酯,24980-41-4,Polycaprolactone
- 南通合润生物科技有限公司 VIP
- 2026-04-05
- 询价
-

- 聚己内酯
- 重庆渝偲医药科技有限公司 VIP
- 2026-04-04
- ¥360
-

- 聚己内酯
- 广州为华生物科技有限责任公司 VIP
- 2026-04-04
- ¥600
-

- 聚己内酯 24980-41-4
- 湖北世腾化工科技有限公司 VIP
- 2026-04-03
- 询价
-

- 聚己内酯43160-25-4
- 武汉鼎信通药业有限公司 VIP
- 2026-04-03
- 询价
-

- 2-氧杂环庚烷酮均聚物
- 湖北恒捷化工有限公司 VIP
- 2026-04-03
- 询价
-

- 聚己内酯
- 武汉克米克生物医药技术有限公司 VIP
- 2026-04-03
- 询价
-

- 聚己内酯微球填充剂再生类医美原料
- 上海临辰医药科技有限公司 VIP
- 2026-04-03
- 询价